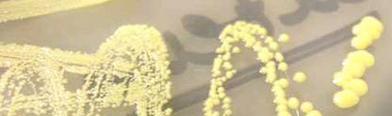

| ||||
Microbiology
from Science Prof Online
 | ||||||
There are several ways to find the information you are looking for on Science Prof Online (SPO):
- 1. Do a keyword search.
- 2. Browse SPO main topics using navigation menus at top of page.
- 3. Go to the Virtual Microbiology Classroom for a full course curriculum.
- 4. Check out the featured microbiology "class notes" articles & virtual classroom resources below.
MICROBIOLOGY GENERAL
Class Notes Articles:
- What Is Microbiology? Study of Microscopic Organisms
Virtual Microbiology Classroom Resources:
- Intro to Microbiology Lecture Main Page
- Microbiology Test Questions - FREE!
MICROBIOLOGY IN THE HOME
- Microbiology In the Home: Tips to Sanitize Your House and Keep Your Family Healthy
- Clean Kitchen Tips: How to Kill Germs & Sanitize Surfaces
How Do I Use This Site?
What Is Microbiology? \mī-krō-bī-ä-lə-jē\
SCIENCE PHOTOS
Page last updated 10/2015
SPO VIRTUAL CLASSROOMS
SCIENCE VIDEOS
Microbiology is the branch of biological science that studies microscopic forms of life as well as non-living infectious particles such as viruses, viroids and prions.
This relatively new science began with the erroneous belief in spontaneous generation and matured into the germ theory upon which our modern understanding of infectious disease is based.
TV show, from Animal Planet, presenting case studies of people with parasitic infections. So interesting, you'll learn about parasitism without even trying!
Check out our FREE
Monsters Inside Me
Homework Assignments
 | ||||||
See a microbiology experiment on how well this steam mop cleans floors.
MICROBIOLOGY LABORATORY SKILLS
"Lab Notes" Articles:
Microscopy
- How to Use a Compound Microscope: Finding & Focusing on Microscopic Objects
- Viewing Bacteria With Microscope Using Oil Immersion
Other Laboratory Equipment
Staining & Identifying Bacteria
Bacterial Culture and Growth Media
- Differential & Selective Bacterial Growth Media: MacConkey's (MAC), Mannitol Salt (MSA) & Blood Agar (BAP)
 | ||||
MICROBIAL METABOLISM & GROWTH
Class Notes Articles:
- Binary Fission: Cell Division & Reproduction of Prokaryotes
Virtual Microbiology Classroom Resources:
- Microbial Metabolism Lecture Main Page
- Microbial Metabolism & Growth Lecture Main Page
- Spillover by Quammen
- Rabid by Wasik & Murphy
- The Viral Storm by Wolfe
- The Ghost Map by Johnson
- Missing Microbes by Blaser
- The Great Mortality by Kelly
-The Great Influenza by Berry
- Pandemics: What Everyone Needs to Know by Doherty
- Deadly Outbreaks by Levitt
- Microbe Hunters by De Kruif
- Wickett's Remedy by Goldberg
- The Dress Lodger by Holman
The SPO website is best viewed in Google Chrome,
Microsoft Explorer or Apple Safari.
Need Help Pronouncing the Crazy Scientific Names of Microbes?
Visit the
 | ||||
The VMC offers homework assignments based on Radiolab podcasts.
RADIOLAB PODCASTS:
HOMEWORK ASSIGNMENTS:
Explore the following topics and learn more about microbes....the good (normal flora), bad (pathogens) and the opportunists. Below are links to the many microbiology resources SPO offers.
If you don't find what you are looking for, just use one of the search boxes.
Virtual Microbiology Classroom Laboratory Exercise Main Pages:
- Microscopy Laboratory Main Page
- Photomicroscopy & the Wright Stain Lab Main Page
- Bacterial Growth Media & Culture Lab Main Page
- Differential & Selective Bacterial Growth Media Lab Main Page
- Gram Stain & Isolation Streak Plate Lab Main Page
- Differential Staining of Bacteria Lab Main Page
- Differential Stains & Specialized Bacterial Growth Media Laboratory Main Page
- Bacterial Identification (Staining, Specialized Media & API-20E) Laboratory Main Page
- Urine Cultures & Bacterial Identification Lab Main Page
- Laboratory Testing for Bacteria on Food Lab Main Page
- Microbial Control: Use of Heat, UV, Antibiotics & Chemicals Laboratory Main Page
- Leukocytes, Antibodies & Blood Typing Lab Main Page
TYPES OF MICROBES
Class Notes Articles:
- What Are Normal Flora? Resident, Transient & Opportunistic Microbes
- Four Bacterial Pathogens of the Genus Clostridium: Infectious Causes of Gas Gangrene, Tetanus, Botulism, & Colitis
- Listeriosis: Listeria Bacterial Food Poisoning
- Whooping Cough Pertussis: How Often is Vaccination Required? DTaP, Tdap & Td
- Clostridium tetani: What Causes Tetanus and When to Get Vaccinated
Virtual Microbiology Classroom Resources:
- Prokaryotes: Meet the Microbes Lecture Main Page
- Eukaryotes: Meet the Microbes Lecture Main Page
- Viruses: Meet the Microbes Lecture Main Page
- Biological Classification Lecture Main Page
VIRUSES
Class Notes Articles:
- What Is a Virus? Structure, Classification & Reproduction
- What Is a Bacteriophage Virus? Phage Host Recognition, Lytic Replication & Lysogeny
- Is It a Cold or The Flu? How To Determine If You Have a Common Cold or Influenza
Virtual Microbiology Classroom Resources:
- Viruses: Meet the Microbes Lecture Main Page
MICROBIAL GENETICS
Class Notes Articles:
Virtual Microbiology Classroom Resources:
- Microbial Genetics Lecture Main Page
HISTORY OF MICROBIOLOGY
Class Notes Articles:
- Antonie van Leeuwenhoek: Microbiology Pioneer
- Koch's Postulates: Scientific Method Linking Microbe to Disease
- Early Germ Theory: Contributions of Leeuwenhoek, Semmelweis & Snow
- Late Germ Theory: Contributions of Pasteur, Lister, Koch, Domagk & Fleming
- Early History of Human Immunology: Discoveries of Edward Jenner & Louis Pasteur
Virtual Microbiology Classroom Resources:
- History of Microbiology Lecture Main Page
TYPES OF CELLS & CELL STRUCTURES
Class Notes Articles:
- Prokaryotic & Eukaryotic: Two Types of Biological Cells
- Prokaryotic Cell: Structures, Functions & Diagrams
- Bacterial Glycocalyx: Capsules & Slime Layers
- External Structures of Prokaryotic Cells: Flagella, Endoflagella, Fimbriae & Pili
- Eukaryotic Cell: Structures, Functions & Diagrams
Virtual Microbiology Classroom Resources:
- Prokaryotic Cell Structure & Function Lecture Main Page
- Eukaryotic Cell Structure & Function Lecture Main Page
Classroom-tested Biology Homework Assignments
FREE from
ScienceProfOnline.com